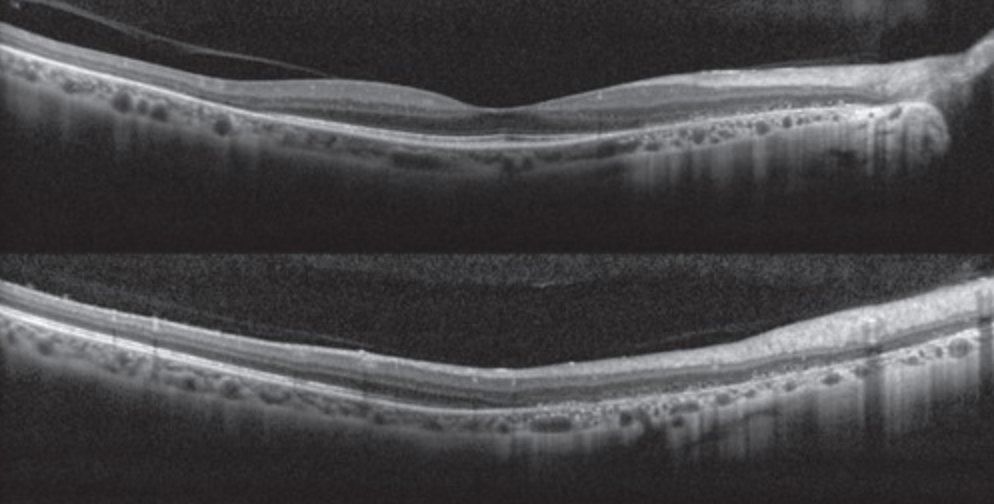
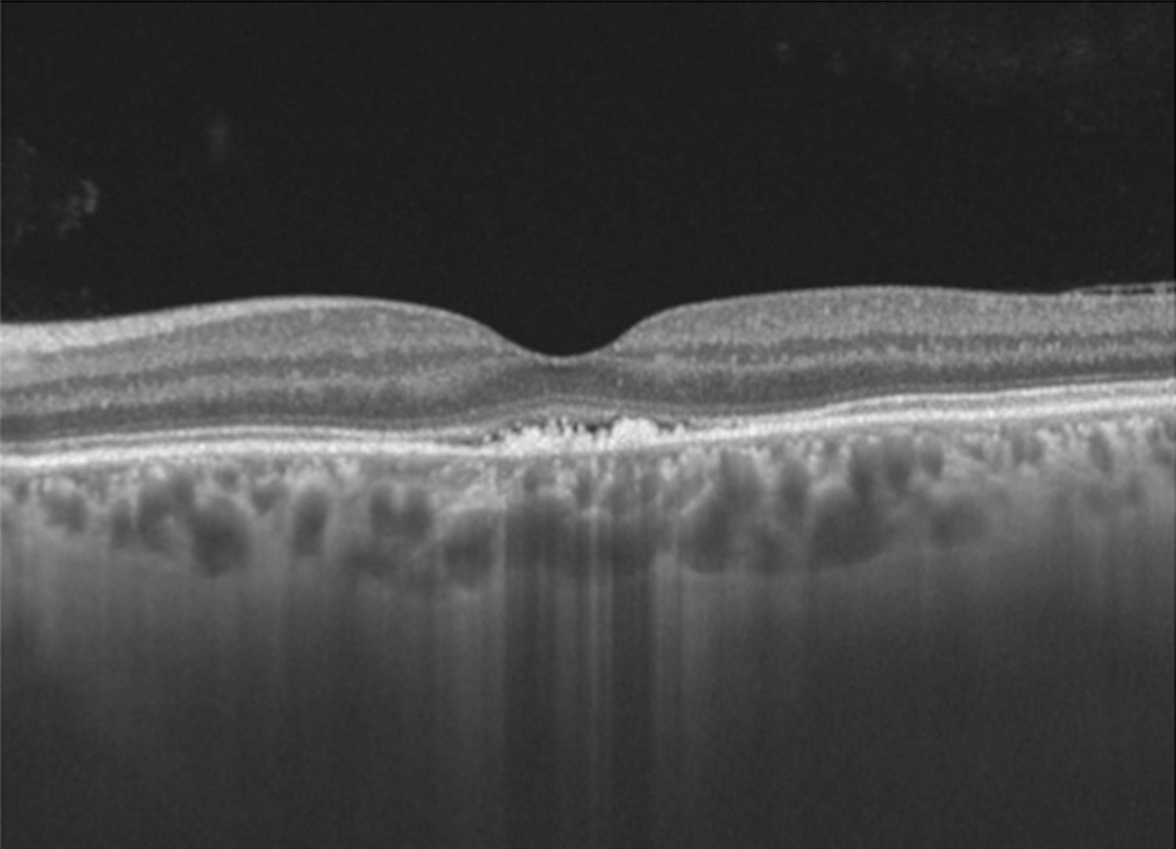

STEROID SAVAGES (+100 each):
- Difluprednate (aka Durezol) QID is equivalent to what frequency of Pred Forte?
- What is the largest limitation of localized steroid therapy (e.g. Ozurdex, STK, etc) -- not cataract or glaucoma
- Walk me through administering STK.
- What is considered a medically safe dose of corticosteroids? What if the patient can't stay quiet at that dose?
- Biggest counseling point (statistics are bonus points) for patients receiving intravitreal steroids?
- Durezol QID = Pred Forte q2h while awake
- Variable duration of effect - only indication of waning effect can be relapse of inflammation.
- Speculum --> 25/27-gauge, 5/8" needle to inject, 21-gauge to draw up --> look down and in (ST approach) --> bevel down, side-to-side movement on entry to ensure no scleral penetration.
- 7.5 mg of prednisone OR topical drug at dose lose enough to avoid ocular side effects. If not quiet, then additional measures needed to be taken.
- 25% require topical anti-hypertensives, 1-2% require filtration surgery due to IOP spike. Cataract development very high in patients (73.8% in Yutiq efficacy/ safety trial).
True/ False:
- Ulcerative colitis is more commonly associated with anterior uveitis than Crohn's
- Formal ophthalmologic screening is recommended in patients with IBD to ensure no uveitis.
BONUS: Topical causes of anterior uveitis (+100 each, max of 300 points)
- True: Anterior uveitis more common with UC (12%) than with Crohns (2%)
- False: Tell the VA / others that eye exam not required without symptoms.
BONUS: Brimonidine, prostaglandin analogues, pilocarpine
Diagnosis (+100)? Most common symptoms (+100)? List four findings that are supportive of the diagnosis (+100 each)
- AZOOR
- Photopsias, enlarged blind spot
- Exam findings: RPE mottling, tilted disc + PPA (myopia)
- FAF with punctate hypoautofluorescence emanating from disc
- OCT: disruption of ellipsoid zone with outer retinal atrophy
Provide a differential diagnosis (at least two) for chronic postoperative intraocular inflammation. +100 for each additional (max +400)
BONUS: What is the most common cause of endogenous endophthalmitis in Asia?
- Persistent postoperative noninfectious inflammation
- UGH syndrome (seen recently with Parish)
- Chronic infectious endophthalmitis (bacterial and fungal)
- Viral anterior uveitis
- Retained lens material
- Vitreoretinal lymphoma
BONUS: Klebsiella from liver abscesses
This applicant was a pitcher and increased his fastball by 4 mph after working with athletic performance trainers. Commended by the National Merit Scholarship. Wrote an article in defense of objective morality grounded by God.
BONUS: This applicant was said to be “the medical student every resident wants to have a chance to work with... a a star student with poise and wisdom beyond his level of training."



Please list as many side effects from systemic steroids (+50 each).
BONUS: What did the FAST trial reveal when comparing methotrexate vs mycophenolate mofetil (aka CellCept) for intermediate and posterior uveitis?
BONUS BONUS BONUS: Per the Uveitis book (Chap 9 in particular), how long does it take for SOME therapeutic response to IMT? How long for full effect?
Ocular hypertension, insomnia, gastric reflux, psychosis, hypertension, hyperglycemia, weight gain, fluid retention
Intermediate/ long-term: Cataracts, avascular necrosis of joints, osteopenia, diabetes
BONUS:
- Methotrexate trended towards more success (66.7%) with treatment compared to CellCept (57.1%) - not statistically significant.
- However, when treating posterior/ panuveitis, MTX statistically significant improvement.
- More adverse side effects with MTX. CellCept is also more expensive FYI.
- CellCept faster time to therapeutic efficacy (4 months vs sometimes 6 months for MTX)
BONUS BONUS BONUS:
- Partial response: 2-4 months
- Full effect: 6-12 months
Viral Associations, Uveitis, and Glaucoma:
- Rubella associated with...
- CMV associated with...
BONUS (+100 each, max of 400): List systemic drug-induced causes of uveitis.
- Rubella --> Fuchs uveitis syndrome
- CMV --> Glaucomatocyclic crisis/ Posner-Schlossman AND Fuchs uveitis syndrome
BONUS: Cidofovir, rifabutin, bisphosphonates, etanercept + adalimumab, systemic fluoroquinolones, sulfonamides, diethylcarbamazine
WDS Fast Facts... (+100 each)
- most associated with CNV?
- further work-up with APMPPE?
- common serpiginous confounder?
- common birdshot confounder?
- WDS with associated retinal vasculitis?
- Most common FA pattern seen in APMPPE, MFC, and serpiginous?
- FA pattern features leakage at the active border?
- CNV: serpiginous choroiditis, multifocal choroiditis, PIC (booo)
- APMPPE: neuro eval with neuro-imaging (rare a/w cerebral vasculitis), CSF studies (rare a/w aseptic meningitis; CSF lymphocytosis observed in pt w/ neuro symptoms + APMPPE)
- Serpiginous: TB
- Birdshot: sarcoidosis (similar chorioretinal lesions)
- Retinal vasculitis: Birdshot chorioretinopathy
- FA pattern: early blockage and late staining
- Leakage at border: serpiginous
Relation of MS to Uveitis (+100 each):
- How much more frequent is uveitis seen in MS patients compared to general population (close enough works)
- Frequency of uveitis in MS patients
- Should you get MRI if typical patient (20-50 year old female) has intermediate uveitis?
- Bilateral or unilateral uveitis in MS?
- 10x more likely if MS
- Up to 30%
- No MRI unless neuro symptoms present
- Bilateral in 95% of cases
WE LOVE THEM KIDS! (+100 each)
- Fire juggler?
- Quadruplet?
- Presented at ARVO and published in Journal of Ophthalmology?
- Fire juggler = Alexander Dague
- Quadruplet = Jacob Beard
- ARVO = Molly Barten
SCLERITIS - MORE LIKE CLARITIS, AM I RIGHT (+100 each):
- Please rate the main subtypes from least severe to most severe.
- How high is the risk of perforation in patients with scleromalacia perforans?
- There is a granulomatous form of necrotizing scleritis with inflammation. With what systemic diseases is this granulomatous form associated?
- SINS? Is/ are they a thing? What is this acronym?
- Diffuse << Nodular << Necrotizing Scleritis
- Low risk of perforation
- Granulomatous --> GPA, polyarteritis nodosa
- SINS - surgically induced necrotizing scleritis
What are the four (4) JIA uveitis screening criteria that determine how frequently kiddos are seen?
BONUS: Visually significant comorbidities to be aware of in kiddos with JIA?
1. Oligoarthritis or nah (four or fewer joints in first six months)
2. Diagnosis PRIOR to seven (7) years old
3. Duration of diagnosis LESS than four (4) years
4. ANA positive
BONUS: Cataracts, glaucoma, band keratopathy
Which white dot syndrome is associated with an enlarged blind spot on VF and a characteristically reversible ERG findings of only a diminished a-wave?
BONUS: Which white dot syndromes may ultimately require immunomodulatory therapy (IMT)?
MEWDS -
1. Reversible ERG findings - only of the WDS
2. Diminished A-wave - isolated "photoreceptoritis" that localizes to the RPE-photoreceptor complex
BONUS: My answer: All except for MEWDS and APMPPE (self-limited). Uveitis book also uses AIM as an exception, too.
What is the management of chronic postoperative endophthalmitis secondary to C. acnes with capsule involvement?
BONUS (+200): What is the rate of endogenous endophthalmitis in patients with candidemia (per a systematic review of more than 1,000 patients identified with rigorous endophthalmitis criteria)
BONUS BONUS (+100): Why the need for rigorous endophthalmitis criteria as cited in the book?
TRIPLE BONUS BRO (+200): What is the AAO's position on candidemia screening?
- Intravitreal antibiotics (namely vancomycin). Vitrectomy may be beneficial. May ultimately require partial or total capsulectomy with IOL explant (!!!) - case-by-case basis
BONUS: <1%
BONUS BONUS: Many patients with candidemia have anemia, low platelet counts, etc that manifest with CWS, intraretinal hemes, pseudo-Roth spots, etc that are NOT related to endophthalmitis
TRIPLE BONUS BRO: Pt must have clinical symptoms (e.g. floaters), signs (e.g. inflammation), or be intubated/ unable to communicate. Routine screening is NOT necessary.
Winner of multiple intradepartmental scholarships in chemical engineering. LOR found them to be "one of the most compassionate students encountered... believe they view a career in ophthalmology as a divine calling, and would absolutely thrive in the faith-based culture of the Scott & White residency program."
BONUS: Which applicant was the winner of the Larry King scholarship, Fulbright Hays Scholarship, and fluent in multiple languages? Participated in three major papers on the SITE trial?

BONUS: 
SIDE EFFECTS, PUHLEASE (Points at my discretion -- back off):
- Cyclosporine/ tacrolimus?
- Cyclophosphamide/ alkylating agents?
- Adalimumab / Humira?
- Infliximab/ Remicade?
BONUS: Please list diseases from chapter 6 that would warrant EARLY IMT initiation (+50 each)
SIDE EFFECTS:
- Cyclosporine: systemic HTN, nephrotoxicity. Tacrolimus less nephrotoxicity.
- Cyclophosphamide: Infertility (visit local egg/ sperm bank, pls) + malignancy risk, hemorrhagic cystitis, opportunistic infections (take Bactrim as prophylaxis)
- TNF: Increased risk of MS, TB/ opportunistic infection, HBV reactivation.
- Remicade: Drug-induced lupus (anti-nuclear antibody development), CHF, systemic vascular thrombosis, etc.
BONUS:
Multifocal choroiditis, serpiginous choroiditis, sympathetic ophthalmia, VKH, Behcets, mucous membrane pemphigoid, birdshot, necrotizing scleritis with systemic vasculitis.
Also basically, any Recko peds patient with uveitis
- First test you think of to confirm diagnosis of TINU? (+200)
- Abnormal lab test seen in TINU (+200)
BONUS: What is the HLA association for TINU?
- Confirm diagnosis: Increased B2-microglobulin in urine +/- eosinophils, abnormal UA
- Elevated serum creatinine
BONUS: HLA-DRB1*01:02
SERPIGINOUS SURVEY (+100 each)!
- Vitreous involvement (yes/ no? extent?)
- "Very useful" method of monitoring? What would be visible? (+100 each)
- IGCA findings?
- Choroidal findings on OCT?
BONUS: 27-year-old woman presents following flu-like illness. Vision is 20/400. Fundus and OCT findings are shown below. Diagnosis? Prognosis?

SERPIGINOUS SURVEY!:
- Minimal to no vitreous cell. Quiet AC.
- Fundus autofluorescence (FAF). Inactive scarring appears hypoautofluorescent. Active appears hyperautofluorescent.
- Hypocyanescent lesions in all phases. May be more extensive than FA.
- Choroidal thickening -- again, inflammation
BONUS: Acute idiopathic maculopathy.
-Vision loss + oftentimes a viral prodrome
-Turbid yellow-gray SRF with pigmentary changes
-OCT with hyperreflective debris in subretinal space +/- SRF.
- Prognosis is good so long as RPE not significantly damaged
70-year-old presents with complaint of floaters. Visual acuity is 20/25 OU. On exam, you notice 3+ vitreous cell that significantly hinders your view to the fundus. OCT Macula doesn't have great signal strength, but no macular edema is present.
What is the most likely diagnosis (assuming this is a standard test question)?
BONUS OF ALL BONUSES (+400): Who wrote Thaonhi Cung's letter of recommendation from BSW (don't even think about saying a word, Thaonithy Brownithy)
Primary intraocular lymphoma / vitreoretinal lymphoma -- classically, very difficult view to the back but patient's vision hardly impaired.
THAONHI: "excellent interpersonal skills... confident and well-composed, friendly, and compassionate. WHOLEHEARTEDLY RECOMMEND."

Who was awarded the Taco Bell Foundation “Live Más” Scholarship 4x Nationally? Additionally, featured by their college newspaper as an “Amazing Student." Would love to spend an afternoon with Lauren Daigle.
BONUS: Who was a part of the American Nuclear Society and enjoys bible study with his wife?
Emily Austin Krueger

BONUS: Mike Jennings
MINI GRAND ROUNDS:
Patient presents with the following. Endorsing 1-2 months of left eye pain and redness. Hx of surgery about 10 months prior. Severe boring pain. Negative systemic ROS. Best next step(s) in management (+400)? Differential (+300)?

BONUS (+300): What is the most common cause of glaucomatous thinning in patients with posterior scleritis?
Next step:
- Culture (scleral scrape vs incisional biopsy) to assess for infectious etiology PRIOR to steroid initiation.
- Check labs (lots)
- Positive for Pseudomonas --> oral + topical antibiotics with subconjunctival injection
- Differential includes: infectious, autoimmune, and SINS
BONUS: Anterior rotation of the ciliary body --> acute angle closure glaucoma
What are both the classic diagnostic triad (+200) of reactive arthritis as well as the additional two major diagnostic criteria (+300)?
BONUS: Pt presents with chronic, post-operative inflammation. You notice phacodonesis, iris TIDs, and 1+ cell despite frequent Pred Forte. You suspect UGH syndrome. What is the most commonly associated ocular condition responsible for the development of UGH (i.e. not a haptic in the sulcus or ACIOL)?
Classic Triad
- Polyarthritis ("can't climb a tree")
- Conjunctivitis ("can't see -- hmmmm") --> usually papillary with mucopurulent discharge
- Urethritis ("can't pee")
- Keratoderma blennorrhagicum - scaly, erythematous rash affecting palms and soles of feet
- Circinate balanitis - scaly circumferential rash of the ol' distal p
BONUS: Pseudoexfoliation syndrome --> instability of the lens-IOL complex --> chafing
BIRDSHOT BRAINTEASERS:
1. What is the characteristic distribution of the lesions in BSCR / BCR (+100)?
2. What tests (besides OCT and FA/ ICG) can be used to monitor the progression of BSCR / BCR (+200 for test, +200 for why)?
BONUS: What is the current academic consensus on the role of HLA-A29 as a confirmatory lab test for _____________? Please eloquently explain this using terms from biostatistics.
BONUS BONUS (+250 mo'): Please provide specific statistics to back up your claim (within 1% of each).
1. Nasal and radial distribution from the optic nerve. Inferior distribution, per retina BCSC.
2. Visual fields and ERG -- specifically, 30-2 flicker implicit time and scotopic b-wave amplitude. Expect prolonged flicker time and reduced b-wave, as the bipolar and Muller affected in birdshot.
BONUS: Buzzin' buzzwords --> LOW POSITIVE PREDICTIVE VALUE. However, HIGH NEGATIVE PREDICTIVE VALUE. Prevalence of HLA-A29 in general population creates the problem. When a disease is rare and lab test is relatively common, there will be a high rate of false positives. However, high association makes negative test valuable.
TLDR: HLA-A29 is necessary but not sufficient for diagnosis of BSCR. If negative, then BSCR ruled out.
BONUS BONUS: 7% of the US population is HLA-A29 positive (biggest issue). Sensitivity is 96%. Specificity is 93%.
Give me all the details behind the most common cause of chronic post-operative endophthalmitis (e.g. Gram positive or negative, rods vs cocci vs other, aerobic vs anaerobic, common chillin' site/ home base)?
BONUS (+200): What is the classic exam finding to raise suspicion for chronic postop endophthlamitis related to C acnes?
BONUS BONUS (+200): Give me the tea about chronic postoperative endophthalmitis and cultures. What if cultures are negative? What should you ask the lab?
BONUS BONUS BONUS (+200): What's the most ridiculous cause of chronic post-op endophthalmitis that was mentioned in the book (many options)?
Cutibacterium acnes. Gram positive rod, anaerobic, commonly found on eyelid skin or conjunctiva.
White plaque within capsule on peripheral lens (between IOL and bag)

BONUS BONUS: Cultures must be retained for a minimum of two weeks due to slow growth. If cultures are negative, consider repeating.
BONUS BONUS BONUS: Candida parapsilosis, Aspergillus flavus, Torulopsis candida, Paecilomyces lilacinus, Verticillium species.
Which applicant worked at Noah's Ark Whitewater Basin?
BONUS: Who claims to be between intermediate and advanced in Spanish fluency? Won his undergraduate's best biology student graduate? Considered a "slam dunk draft pick" with "unlimited potential" in his LoR?
Austin Hagen
BONUS:
